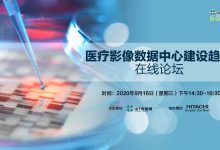

【今日看点】 浙江省人民医院信创探路进行时
突破多院区集团化医院的信创改造难点。
突破多院区集团化医院的信创改造难点。【今日看点】 浙江省人民医院信创探路进行时

医院信息系统具有多目标、开放性的特点,要求基础系统一体化设计。

看病难问题得到持续缓解。

深感庆幸的是,我们行业有一批人真正将“工程技术”的实践体会上升到了“技术科学”。

鼓励探索以“可用不可见”等形式推进健康医疗大数据的应用。

借助信息化手段,打造社会办医疗机构的核心竞争力。

在各类卫生信息系统的支持下,北京的疫情防控做到了科学决策、迅速反应、精准防控。

要把互联网医院打造成医疗服务的重要一环,通过互联网连接诊前、诊中和诊后,为患者提供全流程闭环服务。

打造重大疾病端到端的医疗科技解决方案。

从业务与技术的双重角度,看待HIS创新的得与失。

多个系统直连的接口数不是传说中的n×(n-1)个。

10月24日,再一次相约嘉兴南湖。

数据治理要以数据为中心、以组织为单位,以数据质量为抓手。

活动范围为各级各类民营医院,重点是二级以上民营医院。
盘活“沉睡”的数据资产。

收集、调用个人信息应坚持最小化原则,未经个人信息主体同意不得改变信息用途。

推动信息技术与护理工作深度融合。

通过快速共享120呼救者的移动电话位置信息,有效节省急救调度时间。

基层互联网医疗没有捷径可走,更非一朝一夕之功。

对核酸检测机构目录和采样检测人员数据库实行动态管理。

医院信息化的建设目的,是促进医疗管理的数字化转型,建立医疗质量管理体系。

做好以电子病历为核心的医疗质量和医疗数据过程质量管控,后端的数据分析质量才能得到保障,数据才能客观公正地评价医疗行为。

医疗信息化要蹲下身子为患者服务、为医院赋能、为行业增效。

优化顶层设计,加快实现一数一源、一源多用、整合共享。

“防御+保险”可能是一种更有效的勒索病毒风险解决方案。

展示智慧医院、智慧基层、智慧筛查、智慧慢病四大解决方案。

2020(15th)中国卫生信息技术/健康医疗大数据应用交流大会。

聚合全场景生态资源优势,全面提升医疗机构互联网医院运营能力。

每届展会,参观者最期待的还是捕捉行业的创新热点。

信息化建设,是社会办医疗机构“管理落地”的有力抓手。

“连接一切的能力”,正是医院在构建全新的患者服务与管理模式时所欠缺与亟需的。
最新评论
是的,这需要院内达成一致,领导层面须支持。
非常好,贴合工作实际,有学习借鉴意义。不少年轻人不愿意主动学习,主动思考,主动做事。一是不学习,无能力,二是跟风躺平,做多做少,收入差别不大。
是的
思路很重要,行动更重要
售后服务(治疗,诊疗后有疑问需要咨询医护人员)很好啊,医院应该提供这样的渠道并且不需要收费吧,除非你是土豪,个人觉得,咨询可以有,收费较难接受,利益分配好像也很难合理合规。